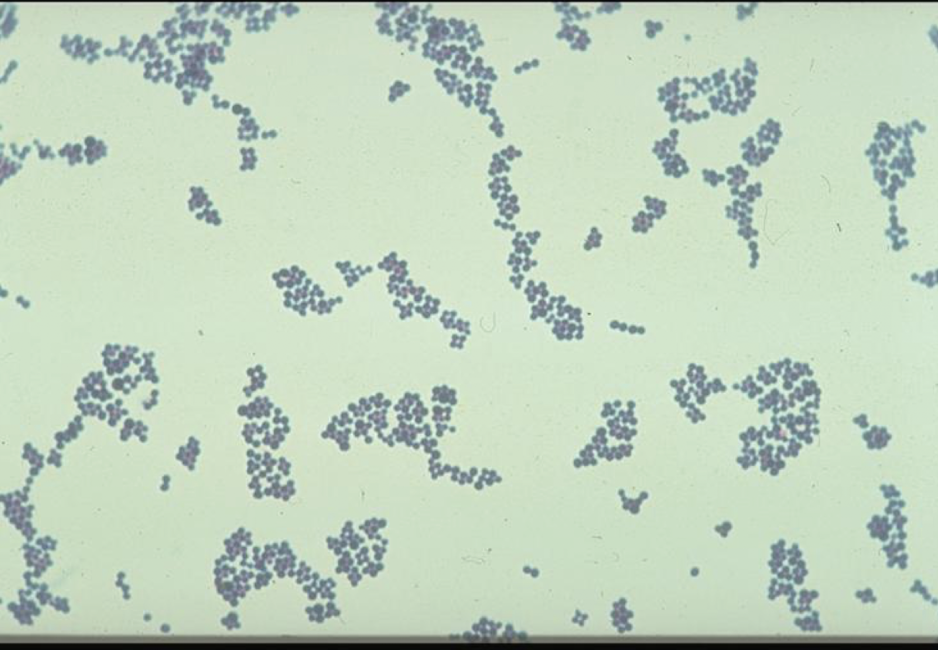
<p><span style="color: purple;"><strong><span>GP cocci</span></strong></span><strong> in grape-like clusters, 0.7-15 µm</strong></p>
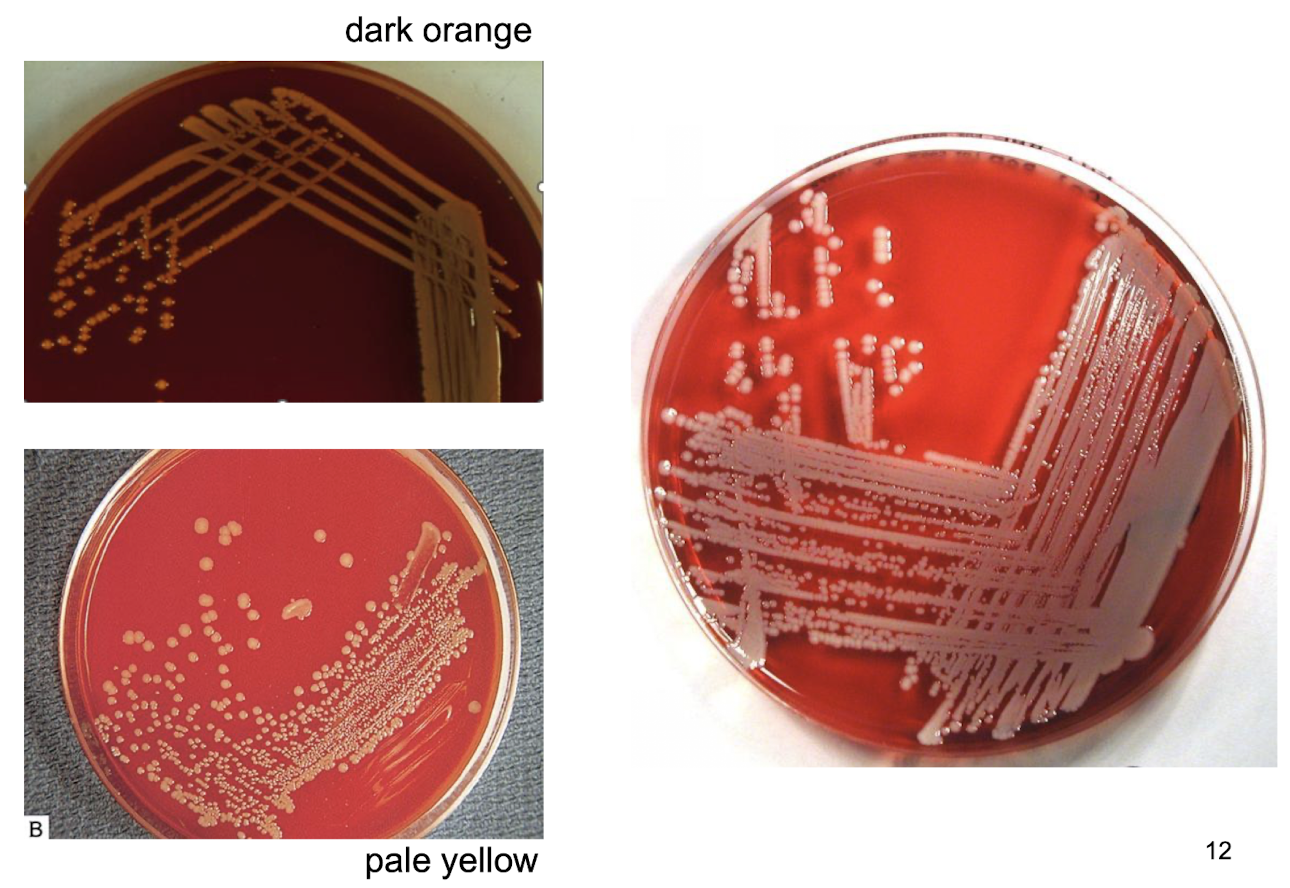
<p><em>S. aureus</em> <mark data-color="yellow" style="background-color: yellow; color: inherit;">(golden) </mark>typically forms <strong><mark data-color="#f3e19e" style="background-color: rgb(243, 225, 158); color: inherit;">golden-yellow colonies</mark></strong> that are<strong> sharply defined smooth, circular, and convex with a creamy texture on culture media 1-4mm in diameter</strong></p><ul><li><p>Exhibit <strong><u>complete haemolytic activity </u></strong>on blood agar, showing a <strong>clear zone</strong> around the colonies.</p></li></ul><p></p>
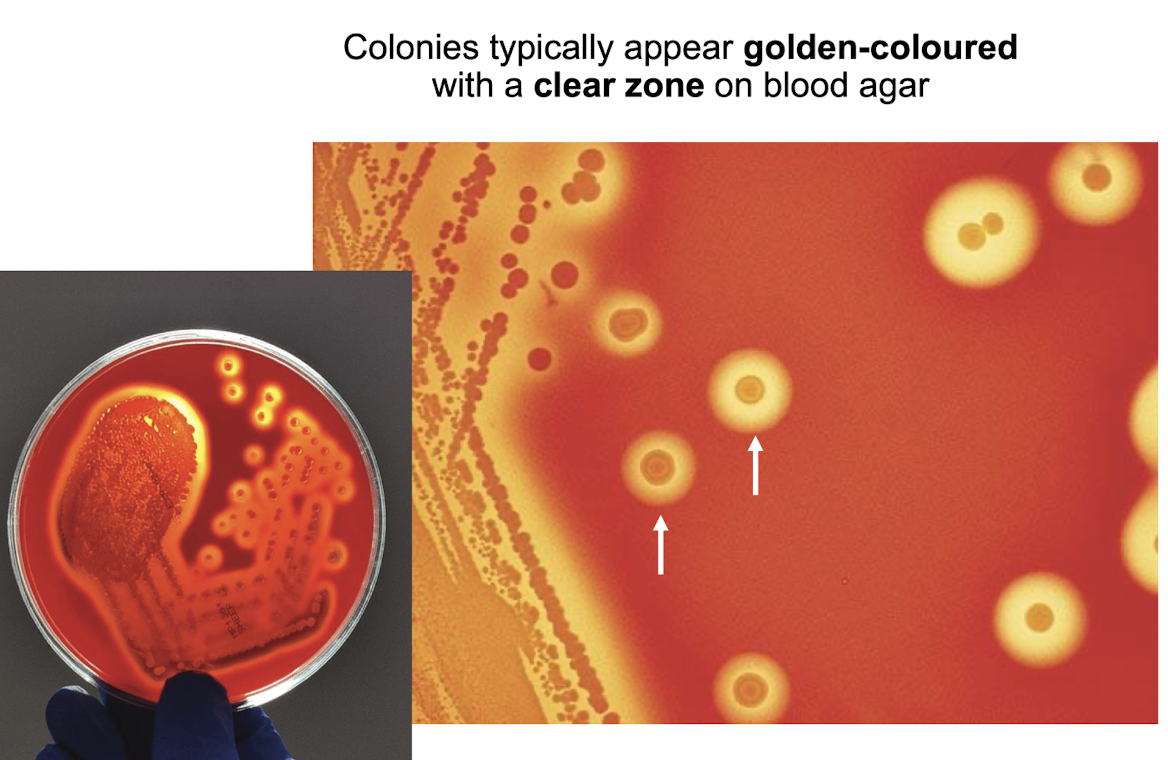
<p><strong>Dependent on the production of carotenoid pigments, primarily <mark data-color="yellow" style="background-color: yellow; color: inherit;">staphyloxanthin</mark>,</strong> which gives colours ranging from pale yellow to dark orange</p>
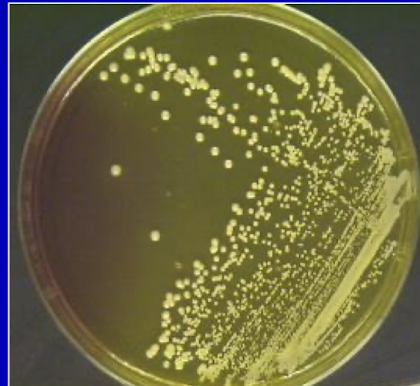
<p><strong><mark data-color="yellow" style="background-color: yellow; color: inherit;">MSA (mannitol salt agar) </mark>which has a high salt concentration which <em>S. aureus </em>is able to grow on, </strong>while inhibiting non-halotolerant bacteria</p><p><strong>Differentiates S. aureus through <mark data-color="yellow" style="background-color: yellow; color: inherit;">mannitol fermentation</mark>, producing <mark data-color="yellow" style="background-color: yellow; color: inherit;">yellow colonies</mark> as <u>phenol red is converted into a yellow colour</u></strong> due to acid production from mannitol fermentation</p>
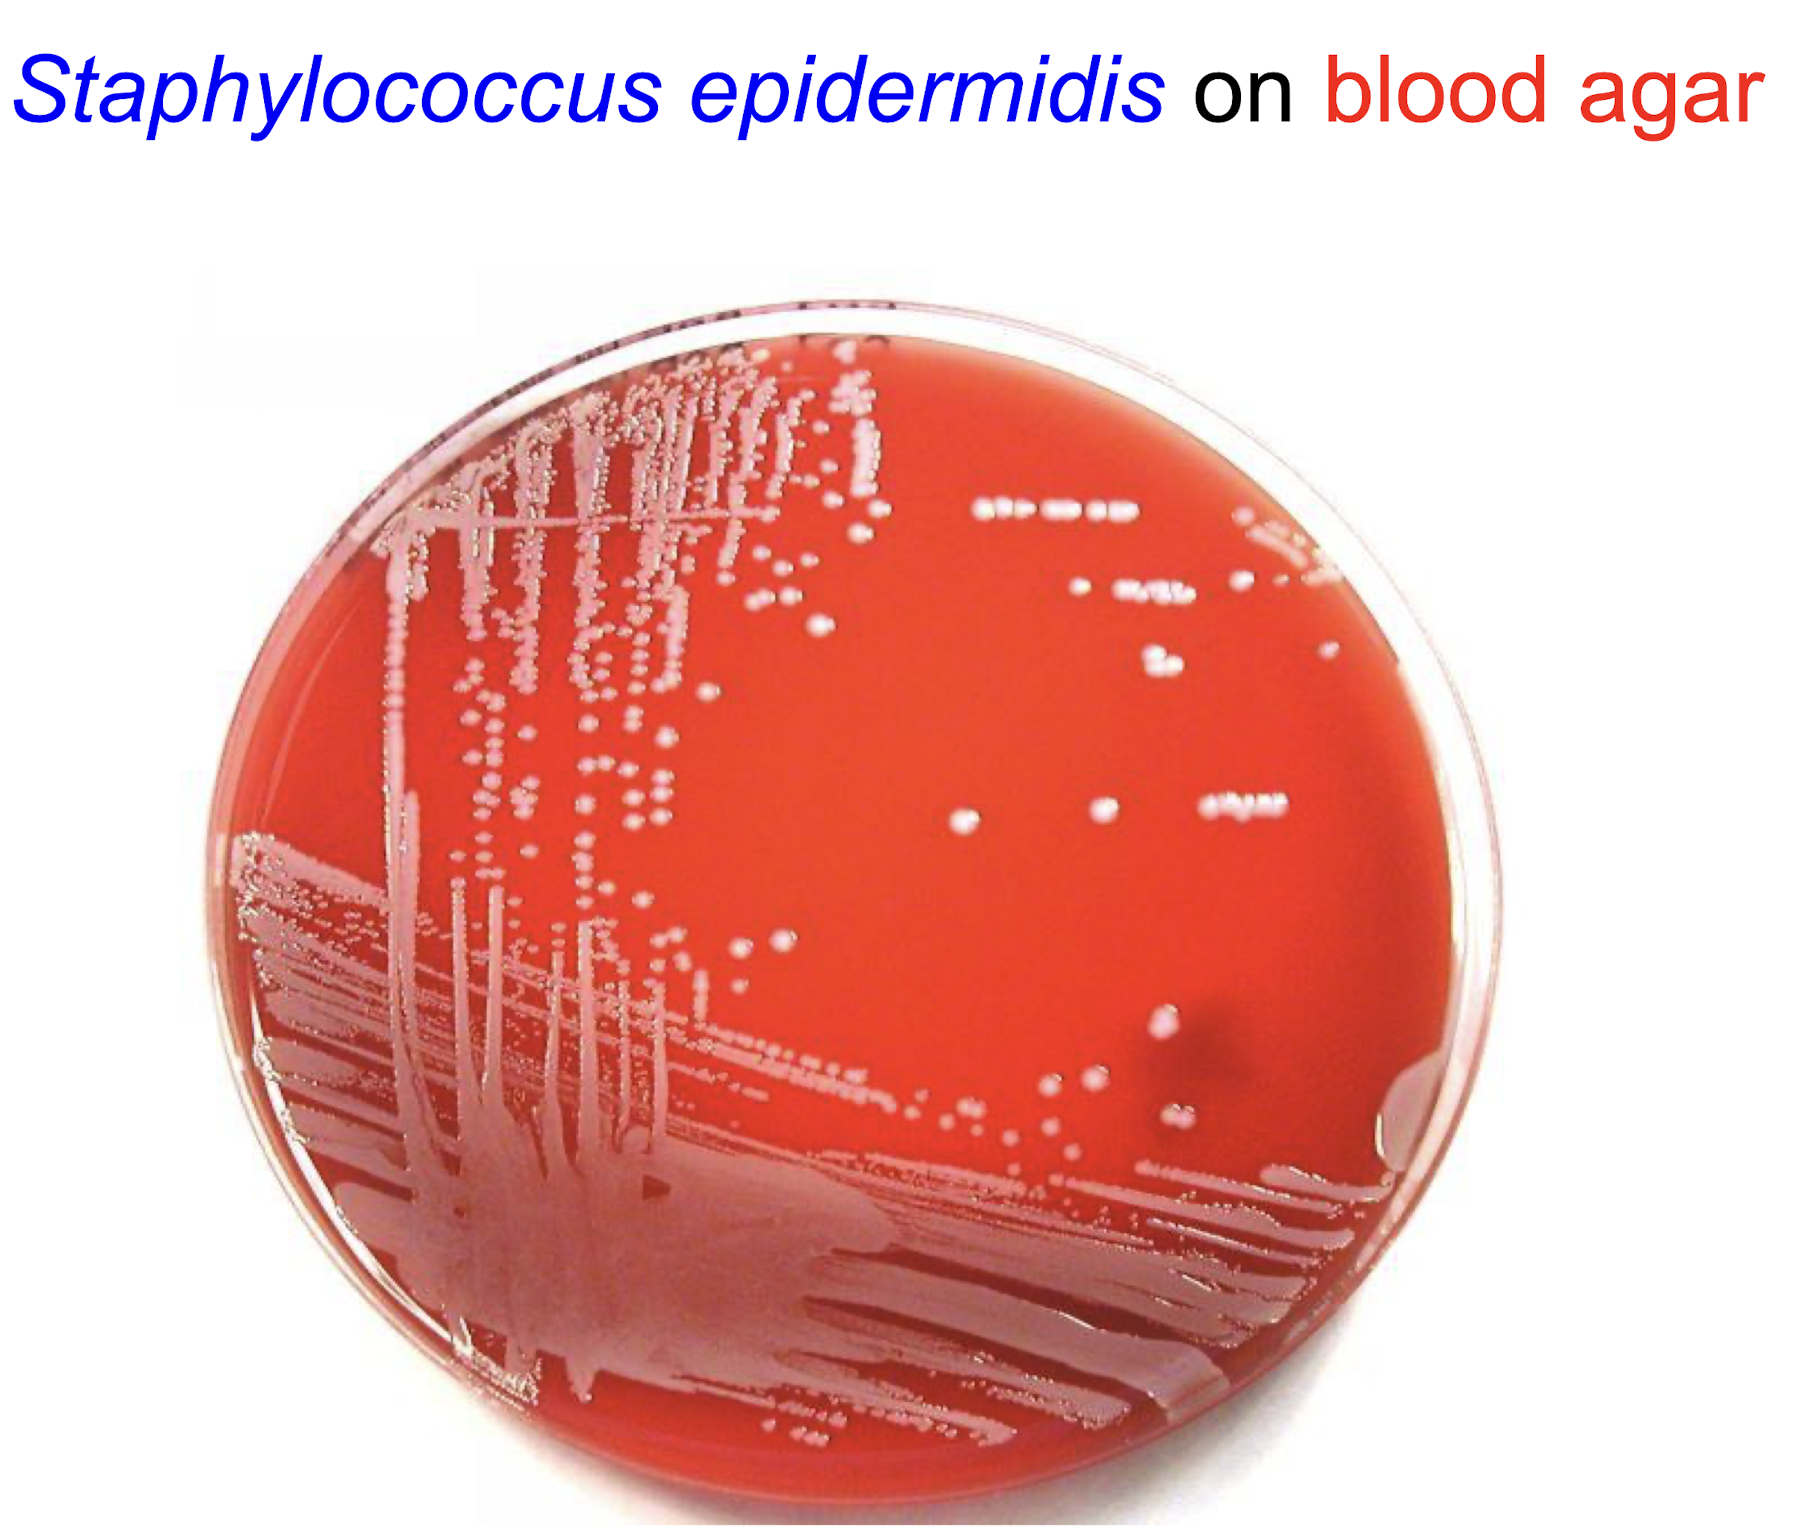
<p><strong><u>Description</u></strong></p><p><strong>– coagulase-negative </strong>(no clumping factor)</p><p>– <mark data-color="purple" style="background-color: purple; color: inherit;">Gram stain features similar to S. aureus</mark></p><p><strong>– white colonies on blood agar </strong>(no complete haemolysis, no staphyloxanthin)</p><p><strong><u>Habitat</u></strong></p><p>– most prevalent and persistent species on human skin and mucous membrane <strong>(normal flora)</strong></p>
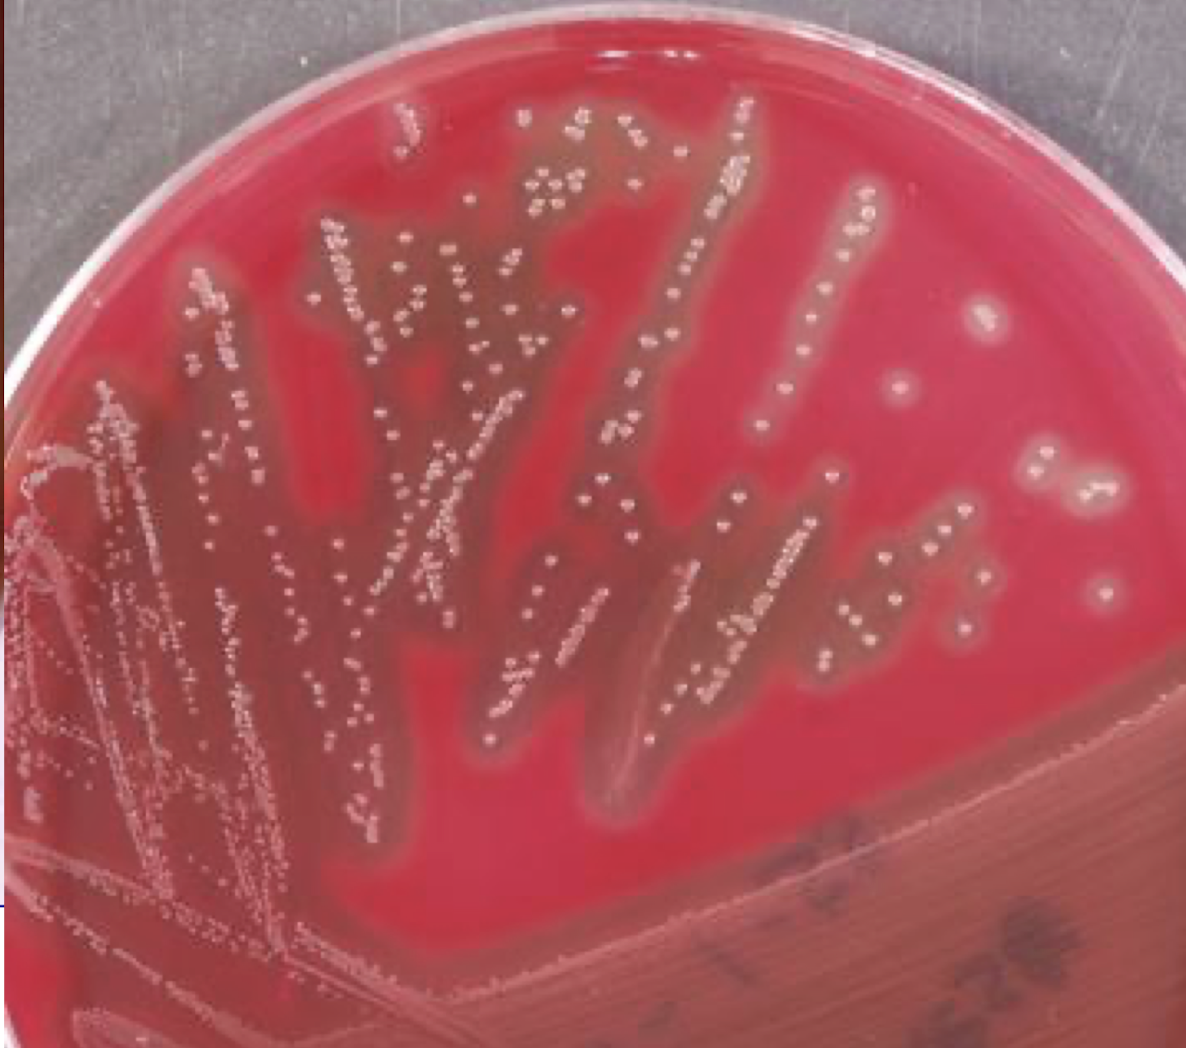
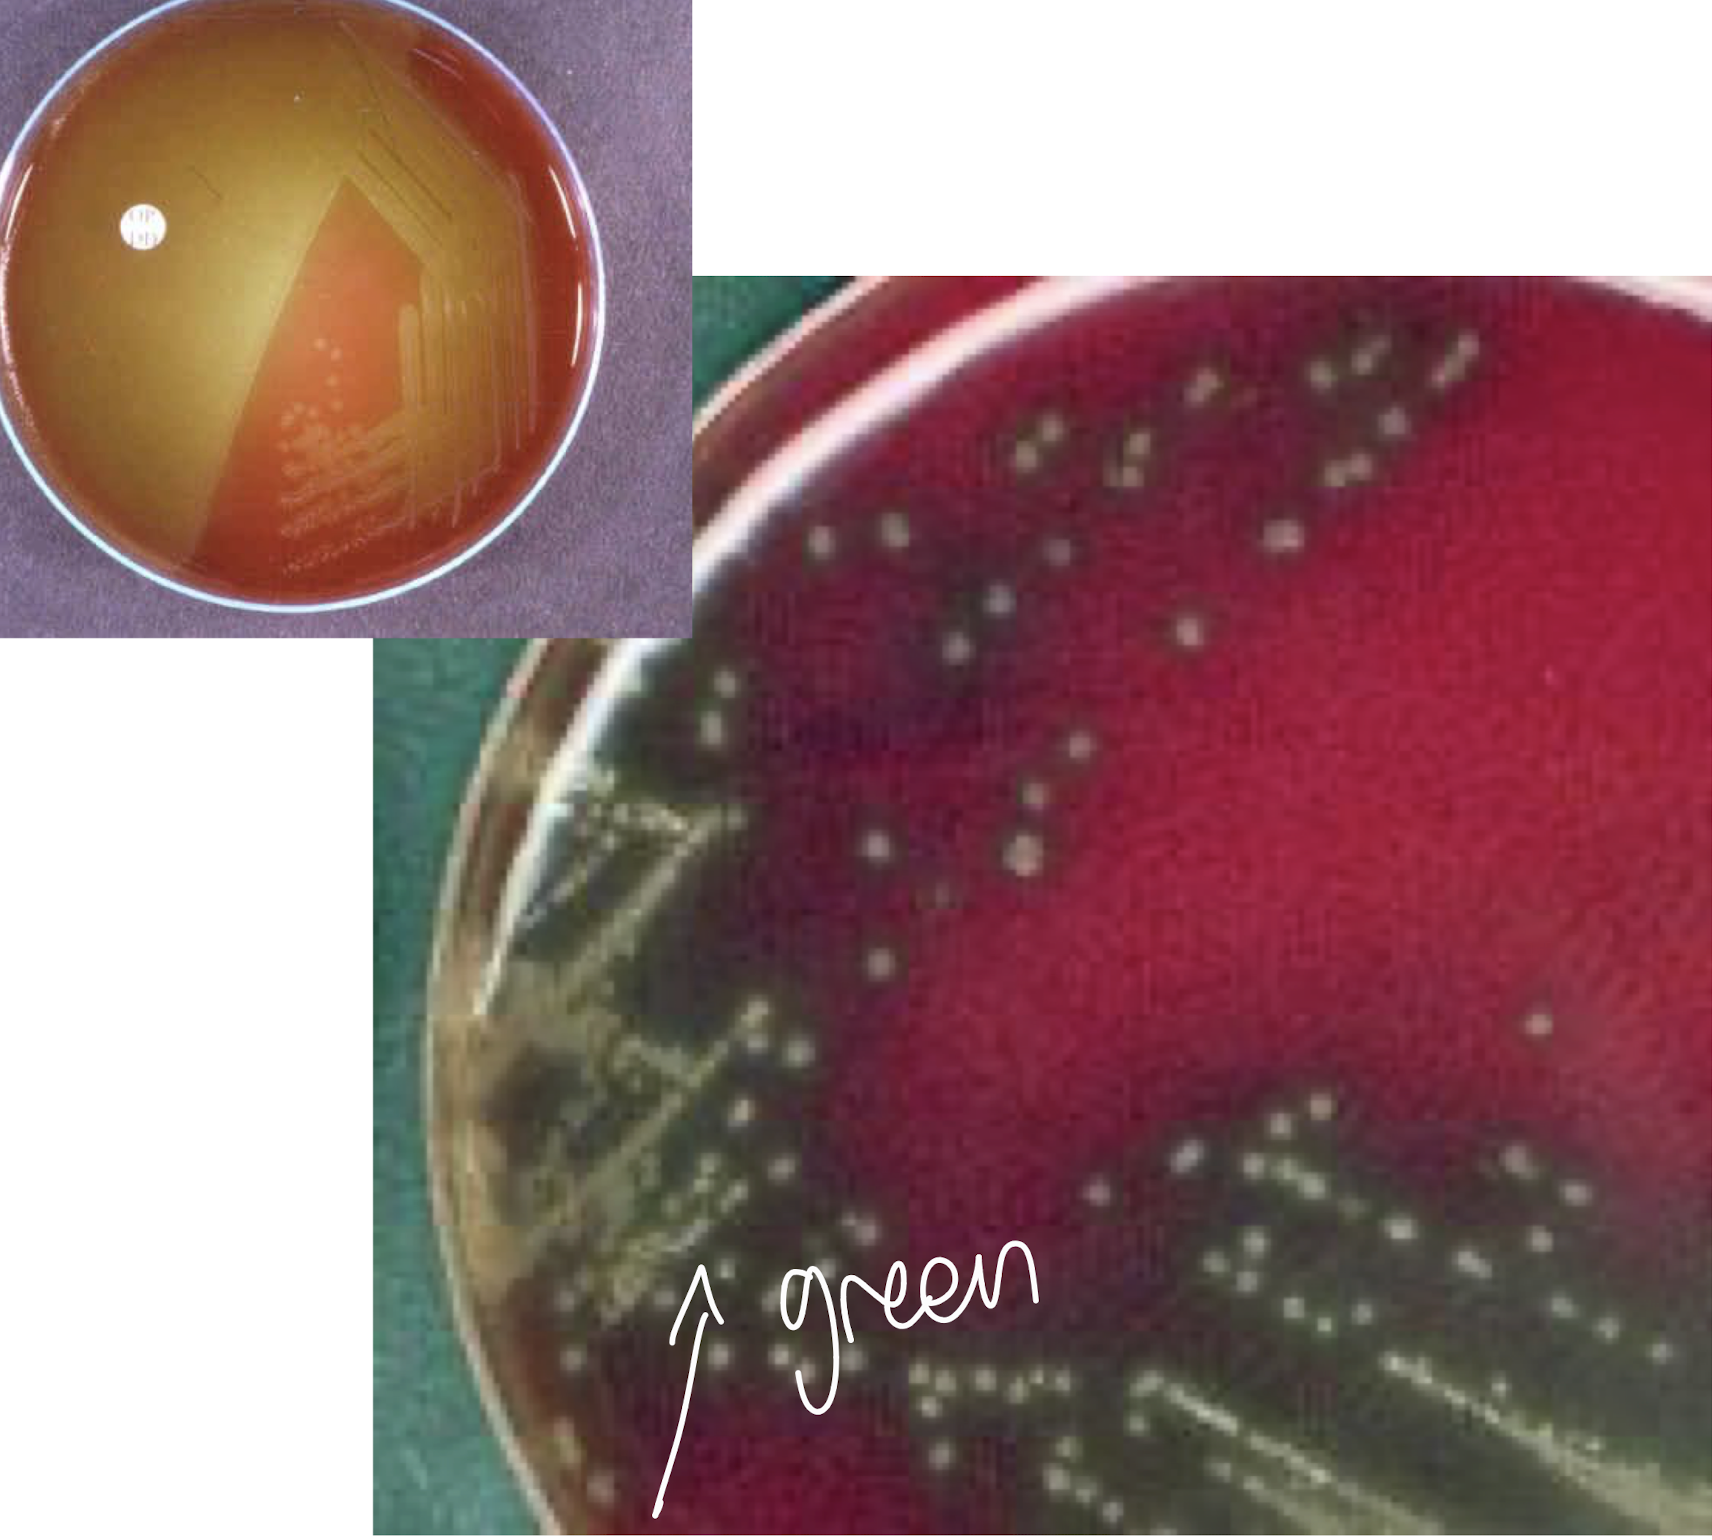
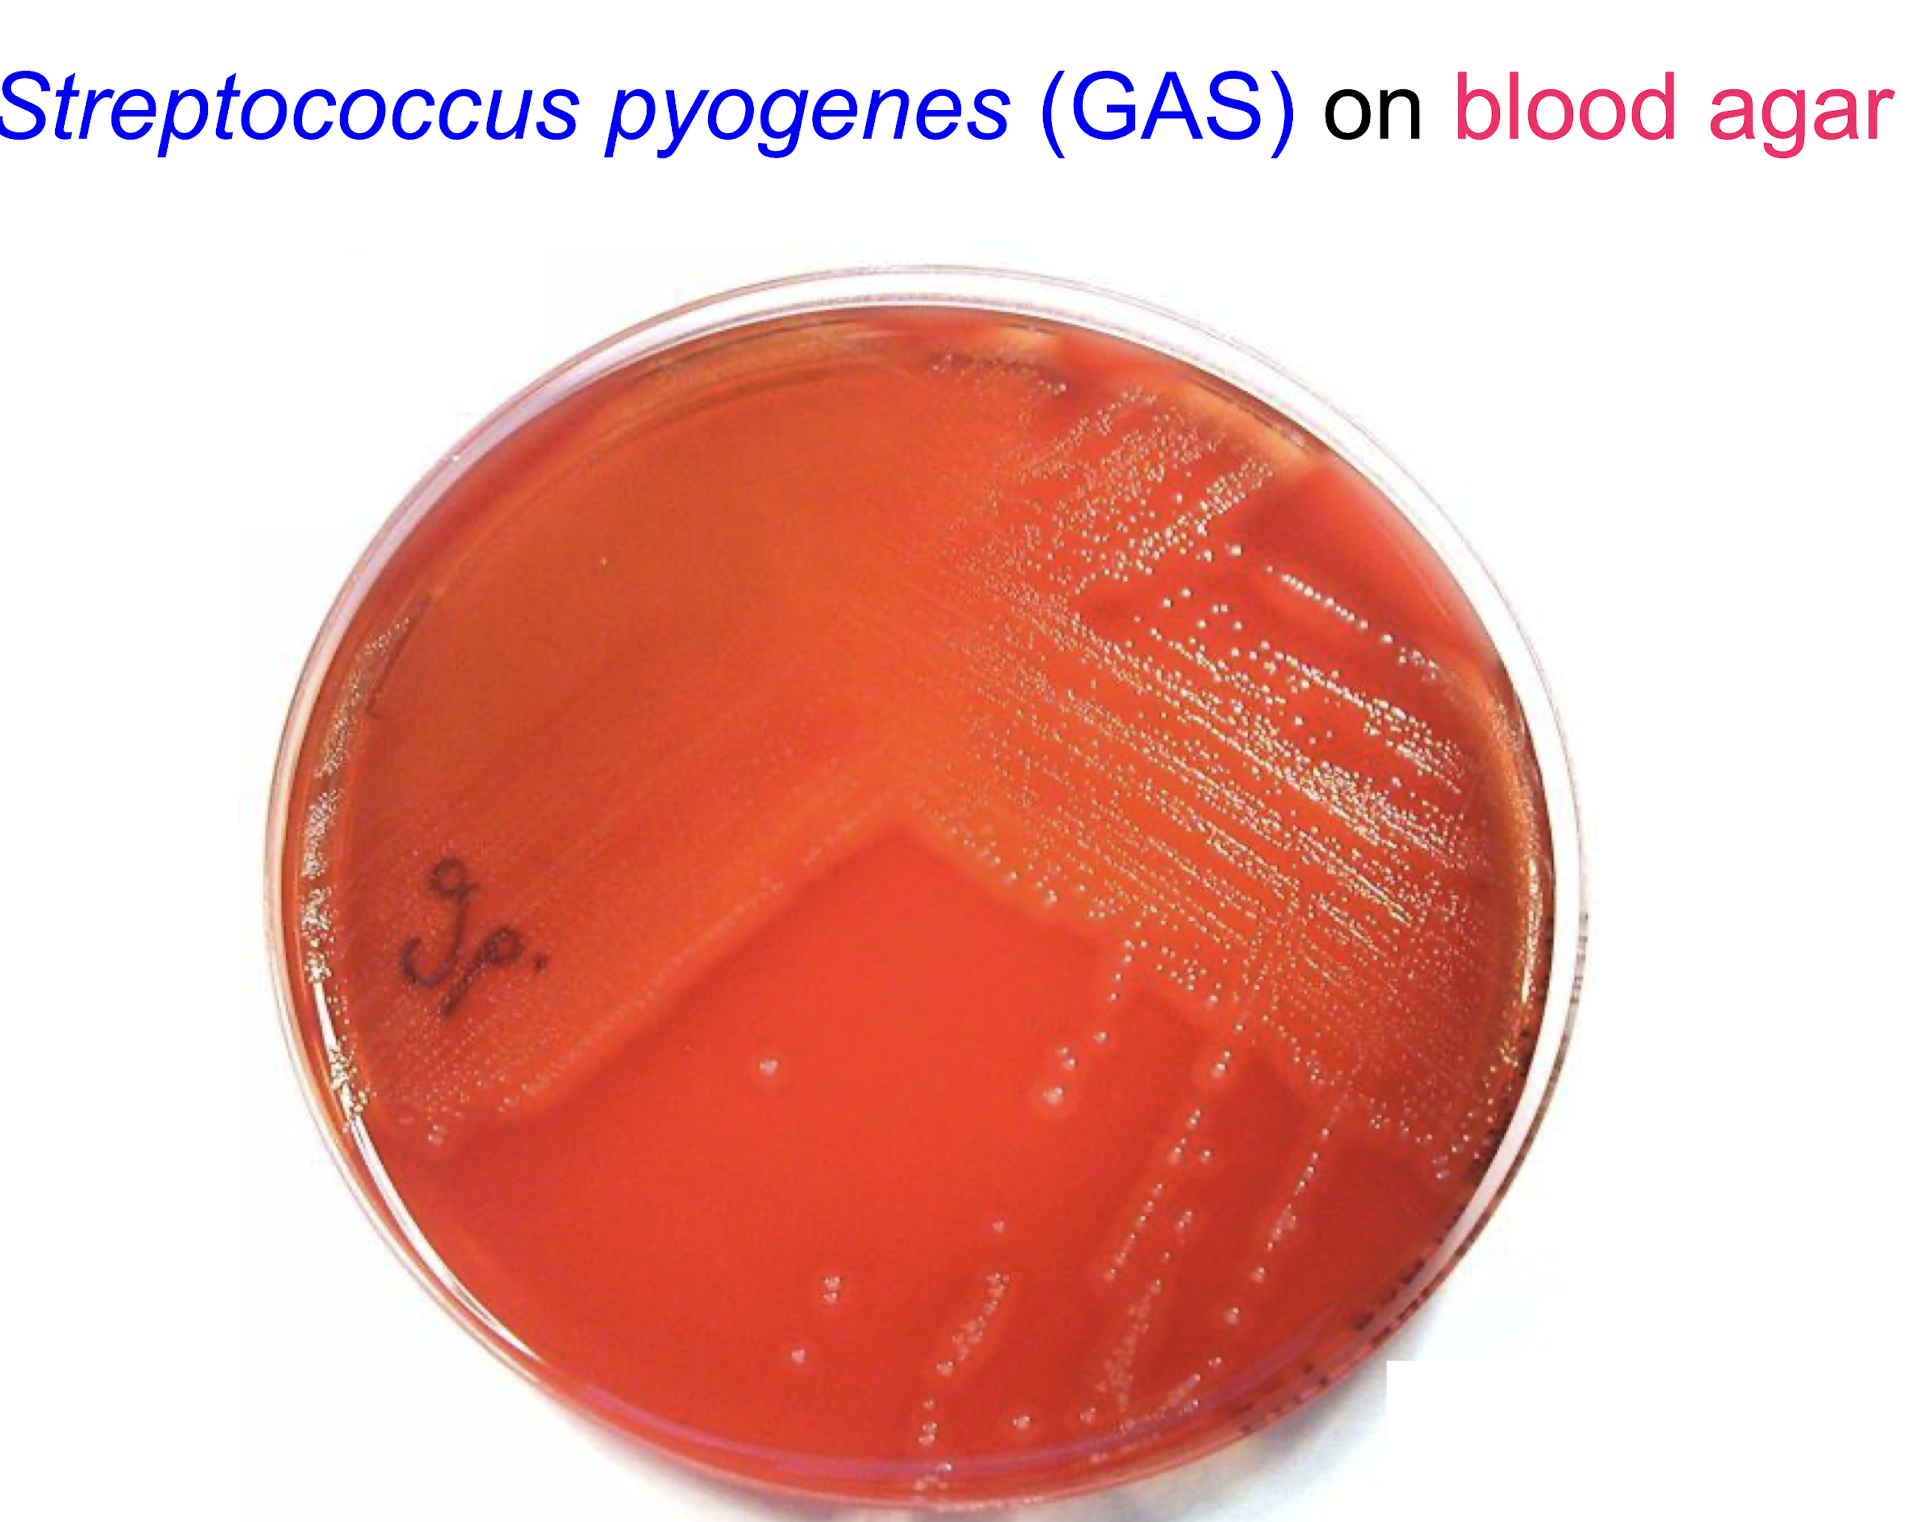
<p><strong><u>Description</u></strong></p><p><mark data-color="purple" style="background-color: purple; color: inherit;">– GP cocci in chains</mark></p><p>– facultative anaerobes</p><p>– cultured on <span style="color: red;">blood agar</span>, show as small grey/greyish white colonies</p><p>• complete / beta haemolysis</p><p><strong><u>Habitat</u></strong></p><p>– nasopharynx</p><p>– children 15-20% carriage rate (adults lower rate)</p><p><strong><u>Virulence</u></strong></p><p>-- M protein</p>
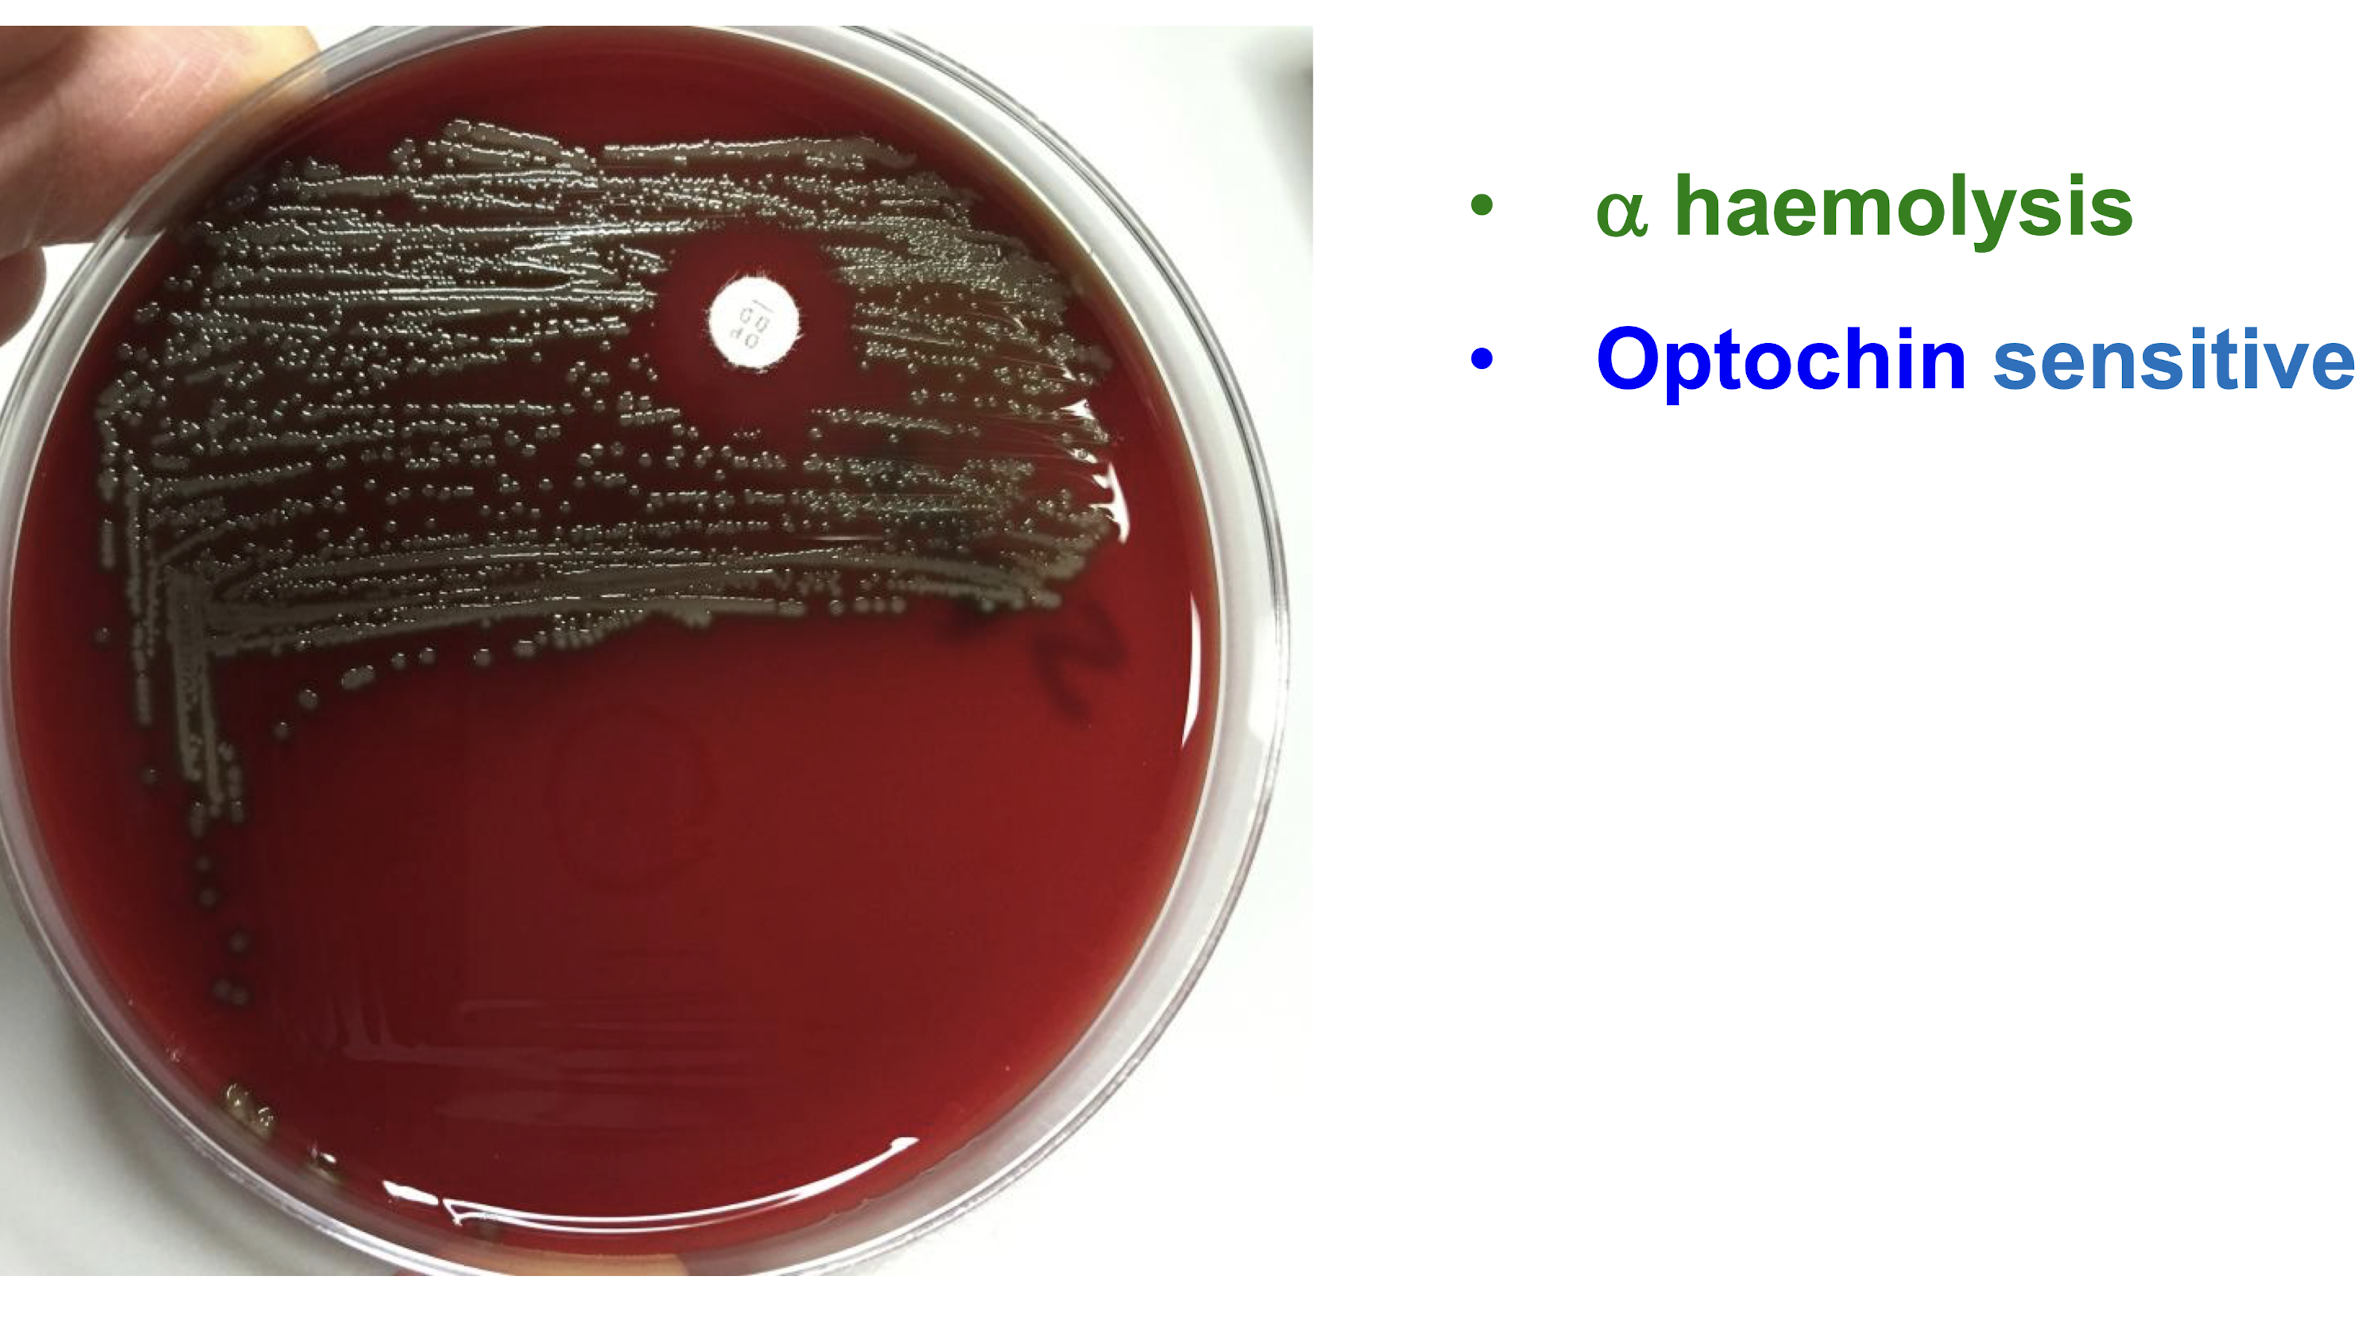
<p><strong><u>Description</u></strong></p><p>– <strong><mark data-color="purple" style="background-color: purple; color: inherit;">GP pneumococcus ovoid or lanceolate cocci in pairs</mark></strong> (diplococci)</p><img src="https://knowt-user-attachments.s3.amazonaws.com/64075840-4380-45aa-99d5-9aab2c1a15f8.png" data-width="50%" data-align="center"><p>– grow well on blood agar</p><p><strong><u>Colony morphology</u></strong></p><p><strong>• small (1mm), circular, raised, smooth</strong></p><p><strong>• </strong><span style="color: green;"><strong>α-haemolysis</strong></span></p><p><strong>– Optochin sensitive</strong></p>
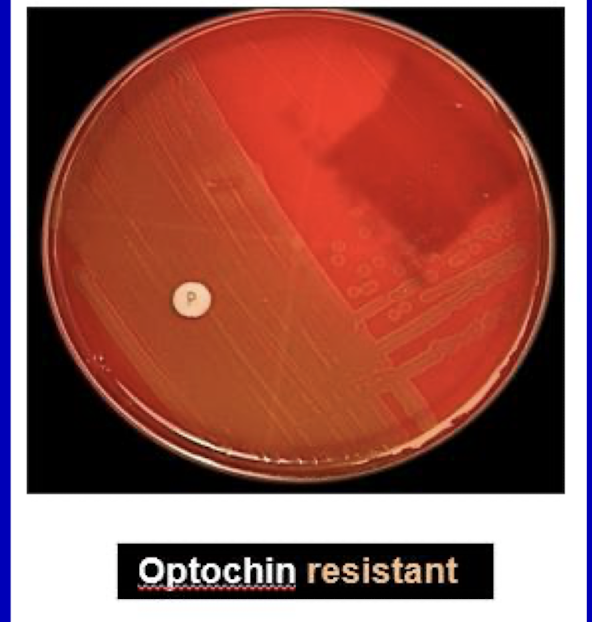
<p><strong>Heterogenous group</strong></p><p>– important species: <em><mark data-color="purple" style="background-color: purple; color: inherit;">S. sanguinis, S. mitis, S. mutans, S. anginosus</mark></em></p><p><span style="color: green;"><strong>• α haemolytic</strong></span></p><p><strong><u>• Optochin resistant</u></strong></p><p><strong>• Normal habitat is oral cavity</strong></p><p><strong>– “oral streptococci”</strong></p>

1/60
Looks like no tags are added yet.
Name | Mastery | Learn | Test | Matching | Spaced | Call with Kai |
|---|
No study sessions yet.
What is the key microscopic appearance of Staphylococcus?
GP cocci in grape-like clusters, 0.7-15 µm
What is the arrangement of Staphococcal species like?
Division in several planes with irregular clusters where the no. of cells varies whereas Streptococcal species form chains in a single plane.

What is a clinically relevant coagulase-positive Staphylococcus species?
Staphylococcus aureus

what are the important coagulase-negative Staphylococcus species?
Staphylococcus epidermidis
Staphylococcus saprophyticus

What are cultural characteristics of S. aureus?
• Culture media used is blood agar.
• Grows well aerobically, less well anaerobically (facultative anaerobes).
• Optimal temperature : 37ºC
What is the typical colonial morphology of S.aureus?
S. aureus (golden) typically forms golden-yellow colonies that are sharply defined smooth, circular, and convex with a creamy texture on culture media 1-4mm in diameter
Exhibit complete haemolytic activity on blood agar, showing a clear zone around the colonies.
what is the colour of S. aureus colonies dependent on?
Dependent on the production of carotenoid pigments, primarily staphyloxanthin, which gives colours ranging from pale yellow to dark orange
What selective media is used to select for S. aureus?
MSA (mannitol salt agar) which has a high salt concentration which S. aureus is able to grow on, while inhibiting non-halotolerant bacteria
Differentiates S. aureus through mannitol fermentation, producing yellow colonies as phenol red is converted into a yellow colour due to acid production from mannitol fermentation
Does S. epidermis exhibit yellow colonies on MSA?
No, S. epidermidis typically forms white colonies on MSA, as it does not ferment mannitol.
What are the main virulence factors of S. aureus?
Cell surface proteins i.e. Protein A, clumping factor
Invasins: e.g. hyaluronidase, staphylysin, leukocidin, leukotoxin, coagulase, staphylokinase
Adhesins: cell-bound proteins
Toxins like TSST, EFT, SEA

How does protein A contribute to S. aureus’ virulence?
Binds with Fc portion of IgG antibodies at the complement-binding site, preventing complement activation
Decreases C3b production, leading to impaired opsonisation and phagocytosis by MPs


What are examples of ECM binding proteins?
– Fibrinogen-binding proteins
– Fibronectin-binding proteins
– Collagen-binding proteins
– Laminin-binding proteins

MSCRAMM =
Microbial Surface Components Recognising Adhesive Matrix Molecules (MSCRAMMs) that enable bacteria to bind to ECM components.

What is the role of extracellular / free coagulase?
Allows for antigenic disguise (i.e. coating themselves with host proteins in order to avoid recognition from immune cells) and converts fibrinogen to fibrin
The wall of fibrin protects it against phagocytosis and helps in the formation of abscesses, facilitating bacterial survival in host tissues.
How is a coagulase tube test formed?
• Tube with diluted plasma
• Add 2 or 3 colonies and incubate for 3-6 hours at 37ºC
Distinct clot made of fibrin forms in coagulase + species

What are the key enzymes in S. aureus virulence?
• Catalase: converts H2O2 to water and oxygen
• Hyaluronidase: hydrolyses hyaluronic acid in a cellular matrix of connective tissue
• Staphylokinase: degrade fibrin
• Deoxyribonuclease: degrades DNA
• Lipase: degrades lipase
• Protease: proteolysis
What are the 5 toxins related to S. aureus?
1. Haemolysins i.e. ⍺, β, δ, γ
2. Panton Valentine (P-V) leucocidin
→ breaks down WBC, causes necrotising skin lesions
3. Enterotoxin -> food poisoning
4. Epidermolytic toxin (exfoliatin)
-> Staphylococcal Scalded Skin Syndrome
5. Toxic Shock Syndrome Toxin (TSST-1)
-> toxic shock syndrome
What are the typical colonisation sites and carriers of S. aureus?
Colonise predominantly the skin, nasopharynx and the vagina
10-35% of carriers are adults (asymptomatic), however carry increased risk for self-infection by the colonising strain
Higher carriage rates among patients with repetitive needle exposure i.e. T1D, IVDU, on haemodialysis, &. those with various skin diseases and health-care workers
What are the 2 types of invasive infections causes by S. aureus?
Direct infection:
Superficial (skin) : folliculitis, furuncles (boils), carbuncle, impetigo, wound infection (typically SSI), cellulitis, abscess
Deep infection: osteomyelitis, septic arthritis, pneumonia
Blood stream infection:
Bacteraemia
Metastatic infection : endocarditis, meningitis, pneumonia, osteomyelitis, arthritis
Folliculitis is an ________________ and a furuncle is a __________ which progresses from a folliculitis
infection of the hair follicles, deep-seated infection in and around a hair follicle that forms a painful nodule or abscess.


Carbuncle
a cluster of interconnected furuncles (multiple hair follicules infected) resulting in a deeper, more extensive infection that affects a larger area of skin.

Impetigo
a highly contagious skin infection often around the mouth primarily affecting children, characterised by red sores that can rupture, ooze, and form a yellow-brown crust.

Cellulitis is caused by S. aureus: True or False?
True, it is an infection of the skin and underlying tissues caused by Staphylococcus aureus, often displayed as a red, spreading infection with an indistinct outline

What are 3 major Toxigenic infections caused by S. aureus?
Staphylococcal food poisoning
Staphylococcal scalded skin syndrome
Toxic shock syndrome
What is the cause of Staphylococcal food poisoning?
• S. aureus inoculated into food that is repeatedly handled (cold meat, custard and creams) by colonised or infected food handler.
• Organisms multiply and produce enterotoxins often when food is left at room temp
• Symptomatic 1-6 hours following ingestion.
• Nausea, vomiting, abdominal pain and diarrhoea.
• Lasts 24 to 48 hours until toxin is eliminated from the body.
What is the cause of Staphylococcal scalded skin syndrome?
• Most common in neonates and children under 8 years.
• Erythema with generalised flaccid bullae (fluid-filled lesion) formation caused by the epidermolytic toxin (a type A+B exfoliatin)
• Spontaneous bullae rupture with skin denudation (desquamation).
• Diffuse dermal involvement

What is linked with increased risk of TSS and how did rates decline?
• Came to prominence in 1980-1981
– Numerous cases associated with super-absorbent (carboxymethylcellulose) tampons used during menstruation (menstrual TSS), allowing S. aureus to grow around the tampon and release TSST-1 toxin
• Newer (cellulose and carbon) tampons, regulations (mandatory labelling), and awareness have helped rates decline in recent years.
– US incidence decreased from 10 to ~1–3 cases per 100,000
menstruating women
What are the symptoms and mortality rates of TSS?
• Characterised by fulminant onset, high fever, erythematous rash with subsequent desquamation, hypotension and multi-organ damage.

• Now, non-menstrual cases associated with localised infections and surgery.
• Mortality 3 to 6%.

What are some different specimen samples / lab investigations that can be used to detect S. aureus?
Specimens
• pus
• sputum
• faeces / vomit or remains of food
• blood cultures
• anterior nasal/ perineal swabs - carriers
• Gram stain
• performed on direct film of pus, swab or sputum
• Culture techniques
• Grow on blood agar - test for haemolysis
• Examine colonies next day
• Test presence of coagulase
• Antibiotic sensitivity test
How are latex agglutination kits used for in detecting S. aureus?
• Detect the presence of protein A and clumping factor.
• Artificially constructed particles coated with IgG and fibrinogen.
• Latex particles rapidly agglutinate to form visible clumps
• Allow for rapid detection in hospital settings and clinical labs.

Characteristics of S. epidermidis:
Description
– coagulase-negative (no clumping factor)
– Gram stain features similar to S. aureus
– white colonies on blood agar (no complete haemolysis, no staphyloxanthin)
Habitat
– most prevalent and persistent species on human skin and mucous membrane (normal flora)
Pathogenicity of Staphylococcus epidermidis
• Adherence to biomaterials by polysaccharides and surface-associated proteins.
•Biofilm formation linked with pathogenesis of polymer-associated infections
– multilayered cell clusters embedded in an amorphous ECM
– protect against host defence mechanisms and antibiotics
How does S. epidermidis form a biofilm i.e. on a catheter / IV line?
Attaches to an unmodified polymer surface via van der Waal’s forces & hydrophobic interactions
Attachment to polymer surface coated with ECM proteins
Proliferation + accumulation in multilayered cell clusters

Where do S. epidermidis infections arise and what can they lead to?
Foreign body infections
• intravenous cannulae
• prosthesis
• CSF shunt i.e. in the treatment of hydrocephalus

– heart valves, joint, vascular
Leading to Endocarditis + bacteraemia from infected IV lines and cannulae

What type of pathogen is Staphylococcus saprophyticus ?
• Urinary tract pathogen
– cause upper and lower urinary tract infection (UTI)
• 2nd commonest cause of UTI in young females (15-20%)
– young sexually active women
What are common features of Streptococcal species?
• Gram positive oval or spherical cocci in pairs (diplococci) or chains that divide in a singular plane

• 0.5 to 1.0µm.
• Blood agar – show haemolysis.
• Small colonies (0.5-2.0mm), grey to greyish white.
• Catalase negative.

How are Streptococcal species classified?
Base on the presence or absence of haemolysis around colonies growing on blood agar and the Lancefield classification system.

What type of haemolysis is this?
Beta haemolysis, characterised by complete lysis of red blood cells, creating a clear zone around colonies on blood agar.
What type of haemolysis is this?
Alpha haemolysis, characterised by partial lysis of RBC, resulting in a greenish discoloration around colonies on blood agar.
What is the Lancefield classification used for?
Only for Beta-haemolytic streptococci
Grouped by their shared cell wall carbohydrates
20 groups (A-H and K-V) based on carbohydrate differences *only A,B,C,D,F,G have clinical relevance
Latex agglutination to differentiate among streptococci species.

What are Streptococci of importance in human infection?
S. pyogenes
S. agalactiae
S. pneumoniae
Viridans streptococci

What Lancefield group is S. pyogenes in?
Group A - Beta-haemolytic
What Lancefield group is S. agalactiae in?
Group B - Beta-haemolytic
Why are S. pneumoniae and Viridans streptococci not under Lancefield grouping?
As they carry out alpha-haemolysis NOT beta-haemolysis and do not exhibit the antigenic structure (carbohydrate differences) used for classification.
What are characteristics of Strep pyogenes? (GAS)
Description
– GP cocci in chains
– facultative anaerobes
– cultured on blood agar, show as small grey/greyish white colonies
• complete / beta haemolysis
Habitat
– nasopharynx
– children 15-20% carriage rate (adults lower rate)
Virulence
-- M protein
Why is M protein a major virulence factor of S. pyogenes?
It is a surface protein that helps the bacterium evade the host's immune system as it is antiphagocytic and promoting adhesion to host tissues.
has more than 80 antigenic forms
Composed of 2 polypeptide chains complexed in an ⍺-helical coiled-coil configuration anchored in the cell membrane

What 2 compounds are responsible for haemolysis by S. pyogenes on blood agar?
Streptolysin S and Streptolysin O are responsible for haemolysis by S. pyogenes on blood agar.
What are Streptococcal pyrogenic exotoxins (SPE)?
A family of superantigens
• SpeA, SpeC, SpeG, SpeH, SpeJ, SpeK, SpeL, SpeM
• Streptococcal superantigen (SSA)
• Streptococcal mitogenic exotoxin Z (SMEZ, SMEZ-2)
Causes
• Streptococcal TSS
• Scarlet fever
What are the 3 major spreading factors associated with S. pyogenes?
• Hyaluronidase - degrades hyaluronic acid
• Deoxyribonucleases - hydrolyse nucleic acid and nucleoproteins
• Streptokinase - converts plasminogen to plasmin + breaks down fibrin
5 main virulence factors of Strep pyogenes?
M protein
Streptolysin O
Streptolysin S
SPE
Spreading factors
Infections of S. pyogenes and associated symptoms
• Acute pharyngitis / tonsillitis - most common cause GAS can lead to severe exudative tonsillitis
• Scarlet fever
• Impetigo, erysipelas (very red skin), cellulitis, sepsis in burns,
necrotising fasciitis
• Toxic Shock Syndrome

Scarlet fever and common symptoms / presentation?
Scarlet fever is characterised by a bright red rash, often accompanied by a sore throat, fever, and a coated tongue “Strawberry tongue” → develops into a ‘peeled tongue;”
The rash typically appears between 12 to 48 hours after the onset of other symptoms.
Circumoral pallor is present, with a pale area around the mouth, while the rest of the body exhibits a fine, sandpaper-like rash.

Symptoms may also include headache and abdominal pain.


What bacteria is linked with necrotising fasciitis?
Streptococcus pyogenes, also known as Group A Streptococcus (GAS), is the primary bacteria associated with necrotising fasciitis, a severe soft tissue infection with extensive oedema, erythema, bullae formation + necrosis

How is GAS like S. pyogenes diagnosed in the lab?
Specimen testing
– throat, pus swab, blood culture analysis
• Direct examination by Gram stain.
• Culture on blood agar at 37ºC.
• Bacitracin sensitivity test replaced by pyrrolidonyl
arylamidase (PYR) test. (GAS is PYR positive).
• Lancefield grouping by commercial kits
What are characteristics of Streptococcus pneumoniae?
Description
– GP pneumococcus ovoid or lanceolate cocci in pairs (diplococci)

– grow well on blood agar
Colony morphology
• small (1mm), circular, raised, smooth
• α-haemolysis
– Optochin sensitive
What is the most significant virulence factor of S. pneumoniae?
Capsule
– polysaccharide structure that protects the bacteria from the host's immune system.
– >90 capsular types
– antiphagocytic
Epidemiology of S. pneumoniae
• Humans are the only known reservoir, colonise nasopharynx
• Spread via respiratory droplets
• Risk factors include age (20-40% of children, less common in adults), immunocompromised state, and chronic lung conditions
Common infections linked with S. pneumoniae
– Pneumonia (commonest bacterial cause)
– Acute exacerbation of COAD (chronic obstructive airways disease)
– Acute otitis media
– Sinusitis
– Meningitis
– bacteraemia - common in splenectomised patients

What is acute otitis media?
It is an infection of the middle ear, commonly linked with S. pneumoniae, characterised by ear pain and potential fever.
It is prevalent in children and can lead to complications if untreated.

Features of Viridans streptococci
Heterogenous group
– important species: S. sanguinis, S. mitis, S. mutans, S. anginosus
• α haemolytic
• Optochin resistant
• Normal habitat is oral cavity
– “oral streptococci”
Common infections linked with Viridans streptococci e.g. S. mutans
Dental caries, plaques and periodontal diseases
Infective endocarditis
Bacteraemia
Deep-seated abscesses